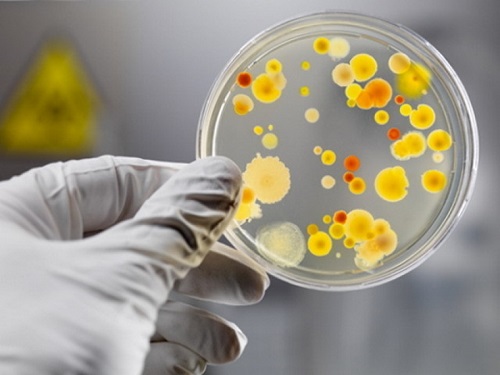

Происшествия | Николаев, 22 Октября, 2020
На Николаевщине в сельских детском саду и школе в приготовленной еде нашли кишечную палочку
Инспекторы Госпродпотребслужбы в Николаевской области внепланового проверилимощности общественного питания в детском саду и школе и отобрали пробы пищевых продуктов для исследования на показатели безопасности.
Результаты исследований не порадовали, сообщили в ГУ Госпродпотребслужбы в Николаевской области, передает Інше ТВ.
Так, в Песковском детском саду (с. Пески, ул. Садовая, 46) по результатам исследования (экспертное заключение от 13.10.2020 г. № 004493 д.у. 20) выявлено несоответствие готовых блюд (картофель отварной, овощи тушеные, котлета рыбная) по микробиологическим показателям (БГКП (колиформы) в 1 г не соответствует ДСП 4.4. 5.078-2001.
В Новопетровской общеобразовательной школе I-III степеней (с. Новопетровское ул. Центральная 4) по результатам исследования (экспертные заключения от 13.10.2020 г. № 004506 д.у./20, №004505 д.у. 20) выявлено несоответствие готовых блюд (капуста тушеная с картофелем, печень тушеная в соусе) по БГКП (колиформы) в 1 г не соответствует ДСП 4.4.5.078-2001, суп картофельный с бобовыми по БГКП (колиформы) в 1 г не соответствует ДСП 4.4.5.078-2001.
Направлены предписания со сроками устранения выявленных нарушений.
- Читайте больше на нашем Telegram-канале. Присоединиться к нему можно ЗДЕСЬ













